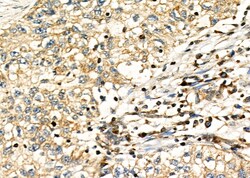
Invitrogen CD33 Polyclonal Antibody 100 &mu;L | Buy Online | Invitrogen&trade; | Fisher Scientific

missing translation for 'onlineSavingsMsg'
Läs mer
Läs mer
Invitrogen™ CD33 Polyclonal Antibody


Beskrivning
Antibody detects endogenous levels of total CD33.
CD33 is a transmembrane protein of the sialic acid-binding immunoglobulin-like lectin (Siglec) family. It belongs to the immunoreceptor tyrosine-based inhibitory motif (ITIM)-containing molecules able of recruiting protein tyrosine phosphatases SHP-1 and SHP-2 to signal assemblies, and these ITIMs are also used for ubiquitin-mediated removal of the receptor from the cell surface. CD33 is expressed on cells of myelomonocytic lineage, binds sialic acid residues in N- and O-glycans on cell surfaces, and is a therapeutic target for acute myeloid leukemia. Further, CD33 is found on granulocyte and macrophage precursors in the bone marrow, but is not on pluripotent stem cells. CD33 is also expressed on, and is a useful marker for, peripheral monocytes. CD33 is useful for distinguishing myelogenous leukemia cells from lymphoid or erythroid leukemias. Diseases associated with CD43 dysfunction include gallbladder lymphoma and extracutaneous mastocytoma.

Specifikationer
Specifikationer
| Antigen | CD33 |
| Användningsområden | Immunohistochemistry (Paraffin), Western Blot |
| Klassificering | Polyclonal |
| Koncentration | 1 mg/mL |
| Konjugera | Unconjugated |
| Formulering | PBS with 50% glycerol and 0.02% sodium azide; pH 7.4 |
| Gen | CD33 |
| Genaccessionsnr. | P20138, Q63994 |
| Gene Alias | CD33; CD33 antigen; CD33 antigen (gp67); CD33 molecule; CD33 molecule transcript; FLJ00391; gp67; Myeloid cell surface antigen CD33; p67; sialic acid binding Ig-like lectin 3; sialic acid-binding Ig-like lectin 3; SIGLEC3; Siglec-3 |
| Gensymboler | CD33 |
| Visa mer |
Produkttitel
Genom att klicka på Skicka bekräftar du att du kan bli kontaktad av Fisher Scientific angående feedbacken du har lämnat i detta formulär. Vi kommer inte att dela din information för andra ändamål. All kontaktinformation som tillhandahålls ska också underhållas i enlighet med vår Sekretesspolicy.
Hittar du en möjlighet till förbättring?